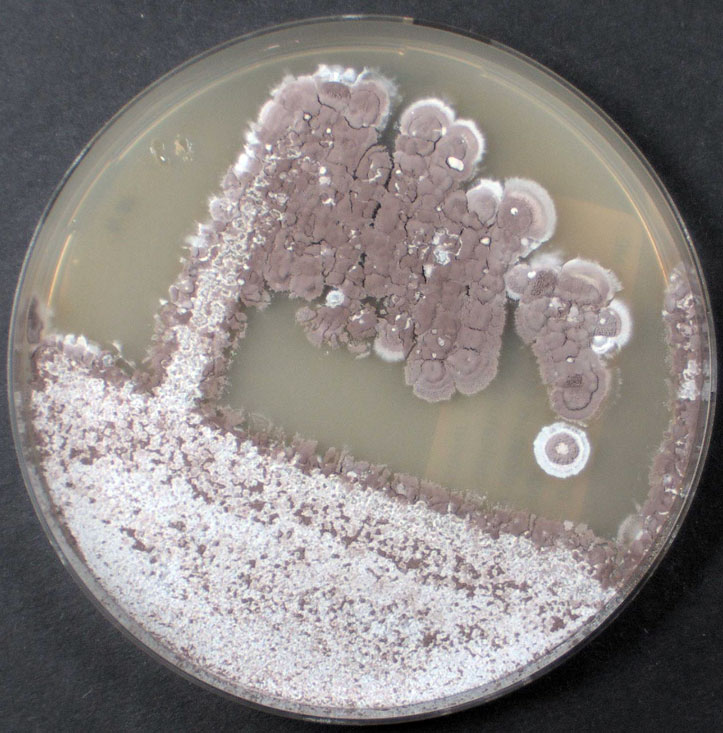
Eine Petrischale mit Kolonien des Bakteriums Streptomyces lonegramiae DSM 41529T

Mikrobiologinnen der DSMZ erhöhen die Sichtbarkeit internationaler Kolleginnen.
Auf der Suche nach Antibiotika-produzierenden Bakterien haben die Wissenschaftlerinnen neue Typstämme der Actinomyceten beschrieben und ausschließlich nach weiblichen Vorbildern benannt.
Mehr Emils als Emilias: Das Gender Name Gap in der Biodiversitätsforschung
Gender Pay Gap, Gender Award Gap, Gender Citation Gap – Gender Gaps sind auch in der Wissenschaft allgegenwärtig. So ist es üblich, dass Forschende ihre Kollegen und Kolleginnen ehren, indem sie neu entdeckte Organismen nach ihnen benennen. Nicht weiter überraschend, dass bisher überwiegend männliche Vertreter ihrer Zunft auf diese Weise honoriert wurden.
Forschende am Braunschweiger Leibniz Institut DSMZ-Deutsche Sammlung von Mikroorganismen und Zellkulturen GmbH um Mikrobiologin und Infect-Net-Mitfrau Prof Dr Yvonne Mast haben diesem Gender Name Gap nun ein wenig entgegengewirkt. Sie haben in einer aktuellen Studie 28 neue Typstämme der Actinomyceten, einer bestimmten Bakteriengruppe, beschrieben und auf ihr Wirkstoffsynthesepotential hin untersucht. Die Neubeschreibungen nutzten Yvonne Mast und ihr Team nun als Gelegenheit, um einigen Kolleginnen und deren wissenschaftlichen Leistungen ein Denkmal zu setzen.
In einer kürzlich veröffentlichten Studie von Kolleg:innen an der DSMZ wurde auf den Gender Gap bei der Namensbenennung von Bakterien aufmerksam gemacht. Dies hatten wir zum Anlass genommen, die neu beschriebenen Stämme ausschließlich nach Wissenschaftlerinnen zu benennen.
Prof Dr Yvonne Mast, DSMZ
Mit Bakterien-Vielfalt werden neue Medikamente entwickelt
Bakterien der Gruppe Actinomyceten gelten als vielversprechende Produzenten von Substanzen mit antimikrobieller Wirkung und damit als wertvolle Ressource für die Entwicklung neuer Antibiotika. Um eine solide Grundlage für weitere wissenschaftliche und pharmazeutische Nutzungen zu schaffen, müssen Eigenschaften und Bedürfnisse der untersuchten Bakterien genau identifiziert und beschrieben werden. Dies ist die Aufgabe der DSMZ-Wissenschaftlerinnen und Wissenschaftler, unter ihnen auch die Mikrobiologin Dr. Imen Nouioui, die die quantitative Dimension dieser Arbeit betont:
Für uns ist die Arbeit vor allem wichtig, da es die erste Studie zur taxonomischen Beschreibung einer so großen Anzahl an neuen Actinomyceten-Arten ist. Normalerweise werden immer nur einzelne oder wenige neue Arten beschrieben. Außerdem sind gerade phylogenetisch besondere Stämme interessant, da für sie ein größeres Wirkstoffbiosynthesepotenzial vorhergesagt wird.
Dr. Imen Nouioui, DSMZ
Die Studie, an der neben Yvonne Mast auch Infect-Net Mitfrau PD Dr. Meina Neumann-Schaal beteiligt war, ist in der Fachzeitschrift Current Research in Microbial Sciences erschienen:
Nouioui I., Boldt J., Zimmermann A., Makitrynskyy R., Pötter G., Jando M., Döppner M., Kirstein S., Neumann-Schaal M., Gomez-Escribano J-P., Nübel U., Mast Y (2024). Biotechnological and pharmaceutical potential of twenty-eight novel type strains of Actinomycetes from different environments worldwide. Curr Res Microb Sci. 2024, 7; doi.org/10.1016/j.crmicr.2024.100290.
René Lesnik | Coordination Infect-Net
